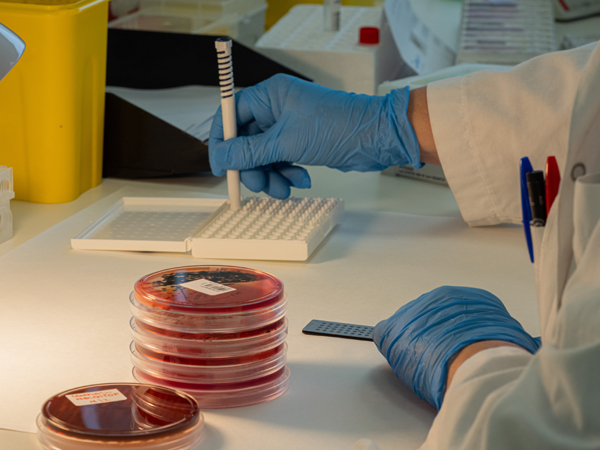

Qualitat i Seguretat del Pacient
Garantim una assistència segura, eficient i centrada en les persones, amb processos basats en evidència científica i millora contínua.
La qualitat en l'atenció i la seguretat dels pacients són aspectes fonamentals per a tots els serveis de salut, per això al Cercle SiS disposem d’un departament específic de Qualitat i Seguretat de Pacients (QiSP).
El sistema de gestió de Qualitat es va iniciar l’any 1986 i, des d'aleshores, s’ha consolidat com un model transversal que treballa conjuntament amb tots els serveis de la institució.
Impulsa eines, metodologies i pràctiques basades en l'evidència científica per garantir la seguretat dels pacients, l'eficiència dels processos i l'alineació amb els estàndards nacionals i internacionals de qualitat.
Com treballem
Els àmbits principals del departament de Qualitat i Seguretat del Pacient són:

Foment d'una cultura institucional basada en la millora contínua de la qualitat i la seguretat dels pacients.

Promoure les bones pràctiques assistencials i avaluar la seva adequació i efectivitat.

Fer el seguiment dels processos assistencials a través d'indicadors clau de seguretat.

Impulsar la cultura de notificació i anàlisi d'esdeveniments adversos de manera participativa i no punitiva.
Promoure la prevenció d'infeccions, convertint-se en referents dins el sector sanitari

Desenvolupar pràctiques segures mitjançant formació i protocols que millorin la seguretat del pacient.

Guiar el compliment de les acreditacions i promocionar models de qualitat i seguretat als diferents entorns assistencials del Cercle SiS.
Fites rellevants del Cercle SiS i del Dpt. de Salut en matèria de Qualitat
Certificacions, acreditacions i avaluacions externes
Laboratori anàlisis clíniques per a la realització de determinacions hematologia, bioquímica, microbiologia, servei de transfusió, diagnòstic per la imatge i servei de rehabilitació.

Acreditacions de societats científiques:
- Unitat d'insuficiència cardíaca
- CONCORDIA – unitat de donació de cordó
- Unitat d’atenció integral de malaltia inflamatòria intestinal
- Unitat d'asma bàsica
- Unitat bàsica del son
- Unitat de ferides
- Unitat del dolor
Acreditacions de centre:
- Certificat d’acreditació de centres d’atenció hospitalària aguda de Catalunya. Aquesta àrea garanteix que tots els processos i serveis compleixin la normativa vigent, així com els requisits d’acreditació externs, donant confiança als pacients i professionals sobre la seguretat i la qualitat de l’assistència.
Infeccions:
- Acreditació de centres en control d’infeccions
- UNE_179006_2013 – Control d'infeccions
Recursos / Documentació relacionada
Aquí trobaràs una selecció de recursos i documents relacionats amb la Qualitat i seguretat del Pacient.
Marc d’actuació del Departament de Salut
Repte estratègic
Repte 2 – Centrada en valor: Aconseguir una organització àgil i engranada focalitzada en pràctiques de valor, sostenible i amb visió de futur.











